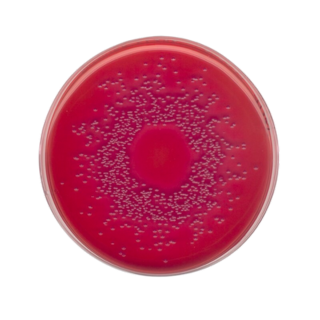

Placas Mac Conkey Agar
- Placas Mac Conkey Agar. Este medio se utiliza para el aislamiento de bacilos Gram negativos de fácil desarrollo, aerobios y anaerobios facultativos a partir de muestras clínicas, aguas y alimentos. Todas las especies de la familia Enterobacteriaceae desarrollan en el mismo. Su fórmula cumple con los requerimientos de la Armonización de Farmacopeas Europea, Japonesa y de los Estados Unidos de Norteamérica (EP, JP y USP respectivamente).
- Codigo:
- Presentación:
OBTENGA INFORMACIÓN ACTUALIZADA SOBRE MONITOREO AMBIENTAL y asesoramiento técnico EN NUESTROS E-BOOKS
CONTÁCTENOS
Argentina:
Buenos Aires. Argentina
Sargento Cabral 2431
Vicente López
CP 1605
Tel: +54 9 11 3027-3162
LATAM
Asunción, Paraguay
Misiones 593 e/ Perú
CP 1102
Tel : +57 310 4594786
EEUU:
Florida. EEUU
1101 Brickell Avenue South, Tower 8th Floor, Miami,
FL 33131
Tel: (305) 381- 1855
Asesoramiento y ventas:
ventas@mikrobiol.com